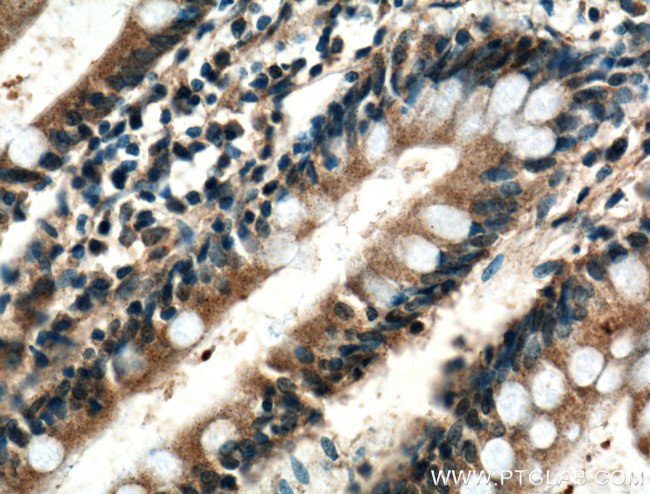
XPNPEP1 Antibody in Immunohistochemistry (Paraffin) (IHC (P))

Search
Proteintech
XPNPEP1 Polyclonal Antibody
{{$productOrderCtrl.translations['antibody.pdp.commerceCard.promotion.promotions']}}
{{$productOrderCtrl.translations['antibody.pdp.commerceCard.promotion.viewpromo']}}
{{$productOrderCtrl.translations['antibody.pdp.commerceCard.promotion.promocode']}}: {{promo.promoCode}} {{promo.promoTitle}} {{promo.promoDescription}}. {{$productOrderCtrl.translations['antibody.pdp.commerceCard.promotion.learnmore']}}
产品信息
10661-1-AP
种属反应
宿主/亚型
分类
类型
抗原
偶联物
形式
浓度
规格
纯化类型
保存液
内含物
保存条件
运输条件
产品详细信息
Immunogen sequence: NSAESEGMR RAHIKDAVAL CELFNWLEKE VPKGGVTEIS AADKAEEFRR QQADFVDLSF PTISSTGPNG AIIHYAPVPE TNRTLSLDEV YLIDSGAQYK DGTTDVTRTM HFGTPTAYEK ECFTYVLKGH IAVSAAVFPT GTKGHLLDSF ARSALWDSGL DYLHGTGHGV GSFLNVHEGP CGISYKTFSD EPLEAGMIVT DEPGYYEDGA FGIRIENVVL VVPVKTKYNF NNRGSLTFEP LTLVPIQTKM IDVDSLTDKE CDWLNNYHLT CRDVIGKELQ KQGRQEALEW LIRETQPISK QH (323-623 aa encoded by BC007579)
靶标信息
This gene encodes the cytosolic form of a metalloaminopeptidase that catalyzes the cleavage of the N-terminal amino acid adjacent to a proline residue. The gene product may play a role in degradation and maturation of tachykinins, neuropeptides, and peptide hormones. Alternative splicing results in multiple transcript variants.
仅用于科研。不用于诊断过程。未经明确授权不得转售。
篇参考文献 (0)
生物信息学
蛋白别名: Aminoacylproline aminopeptidase; aminopeptidase P, cytosolic; cytoplasmic aminopeptidase P; Cytosolic aminopeptidase P; OTTHUMP00000020457; OTTHUMP00000058856; sAmp; Soluble aminopeptidase P; unnamed protein product; X-Pro aminopeptidase 1; X-Pro aminopeptidase 1, soluble; X-prolyl aminopeptidase (aminopeptidase P) 1, soluble; X-prolyl aminopeptidase 1, soluble; Xaa-Pro aminopeptidase 1; XPNPEP1; xpnpep1 {ECO:0000312|RGD:621274}
基因别名: App; APP1; D230045I08Rik; SAMP; XPNPEP; XPNPEP1; XPNPEPL; XPNPEPL1
UniProt ID: (Human) Q9NQW7, (Mouse) Q6P1B1, (Rat) O54975
Entrez Gene ID: (Human) 7511, (Mouse) 170750, (Rat) 170751